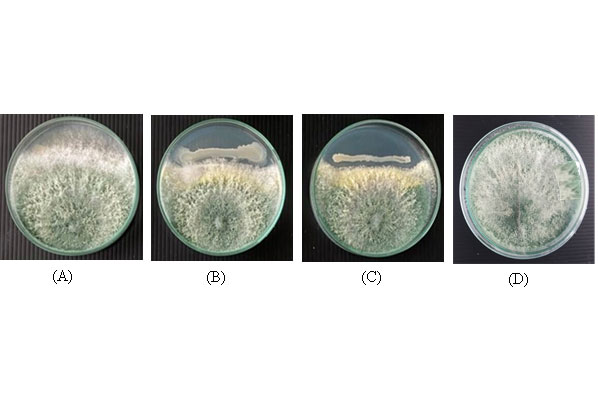

Songklanakarin Journal of Science and Technology (SJST)
Volume 46 No.6 (November - December 2024)
pp. 484 - 557
The 3D LiDAR scanning and speleological analysis of Saen Han Cave, Uttaradit Province, Northern Thailand
Sirinoot Teeranaew, Pichawut Manopkawee, Rattanaporn Fongngern, Tadsuda Taksavasu and Khomchan Promneewat

The efficacy of bioproduct of Bacillus spp. on mycelium growth and controlling green mold disease of Ganoderma lucidum
Wiparat Noochaichaw, Patcharaporn Vanichpakorn and Pornsil Seephueak
Chitosan nanoparticles from three-spot swimming crab shells for cupric ion adsorption from synthetic wastewater
Metta Kengchuwong, Chatyapha Ketwong, Somsuk Trisupakitti, Pornpimol Ponkham, Panuwat Ketwong and John Morris

Evaluation of physicochemical properties of Khao Dawk Mali 105 rice during Germination
Jaturong Langkapin, Sunan Parnsakhorn and Orawan Oupathumpanont

In vitro investigations of chemical composition, antibacterial, antioxidant, antidiabetic, and anti-inflammatory activities of Chromolaena odorata flower extracts
Chi Linh Tran, Kim Thien Duc Chong, Van Mai Do, Van Truong Huynh and Thi Ai Lan Nguyen

Environmental impact assessment of rice production in Indonesia: A case study from Jatibarang, West Java
Indah Permata Sari, Ika Wahyu Utami, Dian Mardi Safitri, Sucipto Adisuwiryo and Ahmad Farhan

Piscine intestinal coccidia: Goblet cell response in juvenile Asian sea bass (Lates calcarifer) across different age groups
Theerayut Thongrin, Sareepah Manmoo and Narissara Keawchana

A new tissue slice technique for evaluation of cardiac tissue enzymes and metabolites
Anitha Nagarajan and Doss VA

Changes in lower limb muscle activity after fatigue protocols during a side cutting movement in subjects with functional instability of the ankle joint
Donlaya Promkeaw, Supannikar Yingyongsaksri, Ploypailin Namkorn and Theerasak Boonwang









